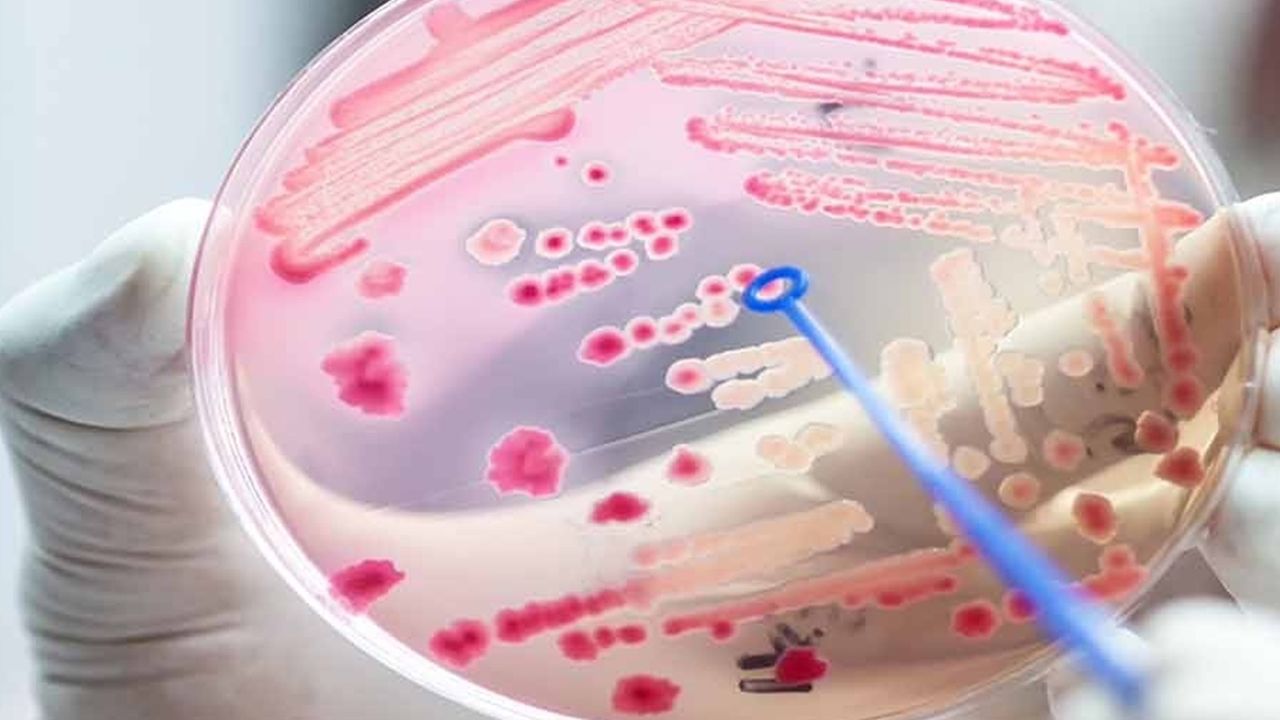

Halk arasında ‘kan zehirlenmesi’ olarak bilinen sepsis sanılanın aksine, vücudun enfeksiyona karşı aşırı tepki verip organlara zarar vermesiyle oluşan ve yoğun bakım tedavisi gerektiren acil bir durum.
Bağışıklık sistemimiz bakteri, virüs veya mantar kaynaklı enfeksiyonlara karşı mücadele etmeyi bırakmasıyla enfeksiyonun tüm vücuda yayılmasıyla başlayan sepsiste ilk bir saat hayat hayati öneme sahip.
Bu rahatsızlığın; ateş, hızlı nefes, kalp çarpıntısı, tansiyon düşüklüğü ve bilinç bulanıklığı gibi belirtilerle ortaya çıktığını ifade eden Anestezi ve Reanimasyon Uzmanı ve Genel Yoğun Bakım Sorumlusu Dr. Tülin Tünel, “Özellikle; bebekler, yaşlılar, kronik hastalıkları olanlar, bağışıklık sistemi zayıf kişiler veya yetersiz beslenenler sepsis açısından yüksek riskli gruplardır.” dedi.
Her yıl dünyada 30 milyondan fazla insanı etkileyen sepsisin; doku hasarı, organ yetmezliği hatta ölüme bile sebep olabildiğini belirten, bu nedenle de sepsisin hızlı teşhis ve tedavi gerektiren ciddi bir tablo olduğunun altını çizen Dr. Tülin Tünel, “Bazen bağışıklık sistemimiz bu enfeksiyonlarla savaşmayı bırakarak kendi dokularına saldırmaya başlıyor. Bu ciddiyet nedeniyle tedavinin yoğun bakımda yapılması gerekir. Hastalar yakından takip edilir ve öncelikle enfeksiyon kaynağı tespit edilir. Tedavi her hastaya özel olarak düzenlese de genellikle hızlı antibiyotik ve sıvı verilmesini, organların çalışmasını desteklemeyi ve gerekli yoğun bakım cihazlarının kullanılmasını içerir.” şeklinde konuştu.
Belirtileri önemsemek septik şoka girmeyi önleyebilir
Uyarı işaretlerinin erkenden tespit edilmesinin vücudun septik şoka girmesini önleyerek hayat kurtardığını dile getiren Tünel, “Sepsis tablosunda; yüksek veya düşük vücut ısısı, bütün gün hiç idrara çıkmama, aşırı titreme, hasta hissetme, şiddetli ağrı veya rahatsızlık, nefes darlığı, ciltte beneklenme ya da renk solması, konuşma zorluğu ya da kafa karışıklığı gibi semptomlar görülebilir. Bu belirtilerin varlığında sepsis şüphesinin kesinleşmesi için bazı testlerle hastanın değerleri de incelenir.” dedi.
Deneyimli ekiplerle tedavide başarı oranı çok yüksek
Ortalama olarak ağır sepsis tanısı alanların yüzde 30’unun hayatını kaybettiğini dile getiren Tünel, “Hayatta kalanlardan yüzde 50'ye yakınının ise sepsis sonrası fiziksel ve/veya psikolojik uzun vadeli etkileri olan bir sendromdan mustarip olduğu biliniyor. Ancak uzman yoğun bakım ekipleriyle sağ kalım oranlarının yüzde 85’e çıktığını da unutmamak gerekiyor. Özellikle sepsis tanısı alan bir hastanın ilk bir saat içinde tedavisine başlanmışsa başarı oranı yüzde 85’in bile üstüne çıkabiliyor.” ifadelerini kullandı.
Dr. Tülin Tünel, enfeksiyon kaynaklı sepsisten korunmanın en iyi yolunun enfeksiyonlara yakalanmamak olduğunu, bunun için de en basit, etkili ve temel önlemin el yıkama olduğunu vurguladı.
Tünel, tam koruma için doğru el yıkamanın püf noktalarını şöyle sıraladı:
"Ellerinizi en az 10-15 saniye boyunca yıkamaya devam edin.
Sabun yerine el antiseptiği kullanıyorsanız, parmak aralarınızı birbirine sürterek temizleyin; başparmaklarınızı ve el üstlerinizi de ihmal etmeyin.
Ellerinizin tamamen kuruması için temiz ve hijyenik bir havlu tercih edin.
Musluğa doğrudan temas etmeyin; kapatmak için kullandığınız havluyu kullanın.
Akan suyun altında ellerinizdeki kirleri ve artık maddeleri uzaklaştırın.
Ellerinizde köpük oluşturarak parmak aralarını, tırnak diplerini ve avuç içlerinizi iyice ovun." (İLKHA)